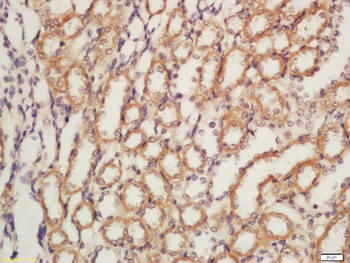
Nephrin Rabbit Polyclonal Antibody

You have no items in your shopping cart.
NPHS1 Antibody
Description
Research Area
Images & Validation
−| Tested Applications | ELISA, IF, IHC-P, WB |
|---|---|
| Reactivity | Human, Mouse, Rat |
Key Properties
−| Antibody Type | Primary Antibody |
|---|---|
| Host | Rabbit |
| Clonality | Polyclonal |
| Isotype | IgG |
| Immunogen | Anti-Nephrin antibody (orb1239664) was raised against a peptide corresponding to 14 amino acids near the carboxy terminus of human Nephrin. The immunogen is located within the last 50 amino acids of Nephrin. |
| Target | NPHS1 |
| Purification | Nephrin Antibody is affinity chromatography purified via peptide column. |
| Conjugation | Unconjugated |
Storage & Handling
−| Storage | Maintain refrigerated at 2-8°C for up to 2 weeks. For long term storage store at -20°C in small aliquots to prevent freeze-thaw cycles. |
|---|---|
| Form/Appearance | Liquid |
| Buffer/Preservatives | Nephrin Antibody is supplied in PBS containing 0.02% sodium azide. |
| Concentration | 1 mg/mL |
| Disclaimer | For research use only |
Alternative Names
−Similar Products
−Nephrin Rabbit Polyclonal Antibody [orb185637]
FC, IF, IHC-Fr, IHC-P, WB
Rabbit
Canine, Human, Mouse, Rat
Rabbit
Polyclonal
Unconjugated
1 ml (Carrier free), 50 μl, 100 μl, 200 μlNPHS1 Antibody [orb1239658]
ELISA, IF, IHC-P, WB
Rat
Human, Mouse
Rabbit
Polyclonal
Unconjugated
0.1 mg, 0.02 mg

Quality Guarantee
Explore bioreagents carefree to elevate your research. All our products are rigorously tested for performance. If a product does not perform as described on its datasheet, our scientific support team will provide expert troubleshooting, a prompt replacement, or a refund. For full details, please see our Terms & Conditions and Buying Guide. Contact us at support@biorbyt.com.

Western Blot Validation in Mouse Kidney Tissue Lysate with the (A) absence or the (B) presence of blocking peptide. Loading: 15 µg of lysates per lane. Antibodies: Nephrin orb1239664 (1 µg/mL), 1h incubation at RT in 5% NFDM/TBST. Secondary: Goat anti-rabbit IgG HRP conjugate at 1:10000 dilution.

Western Blot Validation in Human and Mouse Cell Lines. Loading: 15 µg of lysates per lane. Antibodies: Nephrin orb1239664 (2 µg/mL), 1h incubation at RT in 5% NFDM/TBST. Secondary: Goat anti-rabbit IgG HRP conjugate at 1:10000 dilution.

Immunohistochemistry Validation of Nephrin in Mouse Kidney Tissue. Immunohistochemical analysis of paraffin-embedded mouse kidney tissue using anti- Nephrin antibody (orb1239664) at 1 µg/ml. Tissue was fixed with formaldehyde and blocked with 10% serum for 1 h at RT; antigen retrieval was by heat mediation with a citrate buffer (pH6). Samples were incubated with primary antibody overnight at 4°C. A goat anti-rabbit IgG H&L (HRP) at 1/250 was used as secondary. Counter stained with Hematoxylin.

Immunofluorescence Validation of Nephrin in Mouse Kidney Tissue. Immunofluorescent analysis of 4% paraformaldehyde-fixed mouse kidney cells labeling Nephrin with orb1239664 at 10 µg/mL, followed by goat anti-rabbit IgG secondary antibody at 1/500 dilution (red).

Immunohistochemistry Validation of Nephrin in Rat Kidney Tissue. Immunohistochemical analysis of paraffin-embedded rat kidney tissue using anti- Nephrin antibody (orb1239664) at 5 µg/ml. Tissue was fixed with formaldehyde and blocked with 10% serum for 1 h at RT; antigen retrieval was by heat mediation with a citrate buffer (pH6). Samples were incubated with primary antibody overnight at 4°C. A goat anti-rabbit IgG H&L (HRP) at 1/250 was used as secondary. Counter stained with Hematoxylin.

Immunofluorescence Validation of Nephrin in Rat Kidney Tissue. Immunofluorescent analysis of 4% paraformaldehyde-fixed rat kidney tissue labeling Nephrin with orb1239664 at 20 µg/mL, followed by goat anti-rabbit IgG secondary antibody at 1/500 dilution (red) and DAPI staining (blue).

Apoptosis Assay Validation of Nephrin in Mouse Glomerulus (Chen et al., 2017). Glomerular cells of Atgl (-/-) mice were double labeled with TUNEL staining (dark brown nucleus indicated by red arrows) and immunofluorescence staining of nephrin detected by anti-nephrin antibodies (orb1239664) (pink cytoplasm indicated by green arrows) as a marker for podocytes. Colocalization of TUNEL-positive cells and nephrin proved that apoptosis was induced in Atgl (-/-) mice as compared to WT mice.

Immunolocalization Validation of Nephrin in Human Placenta (Yun et al., 2015). Immunofluorescence staining showed Nephrin expression detected by anti-nephrin antibodies (orb1239664) was clearly localized in villi (A-C) and fetal membranes, Amnion (J-L) and Chorion (M-O). The staining was markedly positive at apical membrane of villi (arrows in B and C) and amnion (arrow in L), and in the stromal cells of chorion (small arrow in O).

Immunofluorescence Validation of Nephrin in Mouse Podocyte (Li et al, 2013). Double immunofluorescence analysis of podocytic membrane protein nephrin (red) and nuclei stained with DAPI (blue). The presence of high glucose (HG) and neutralizing antibody (NtAb) which blocked epithelial growth factor (EGF) decreased nephrin expression while mesenchymal stem cells-conditioned medium (MSCs-CM) and recombinant human EGF (rhEGF) prevented the effect.

Induced Expression of Nephrin by Curcumin Treatment in the Renal Tissues of Type 1 Diabetic Rats (Soetikno et al., 2013). Nephrin expression detected by anti-nephrin antibodies in type 1 diabetic rats. Nephrin was down-regulated in the vehicle-treated diabetic rats as compared to the control nondiabetic rats. However, this decreasein nephrin protein expression was markedly increased by curcumin treatment (P <.05) to near-normal levels. (n = 5 in each group).

Immunofluorescence and Localization Validation of Nephrin in Cultured Rat Podocytes (Piwkowska et al., 2012). Immunofluorescence staining showed Nephrin expression (green) detected by anti-nephrin antibodies and PKGIalpha (red). The co-localization of two antibodies (yellow) in rat podocytes was observed particularly at the tips of the cell processes.

WB Validation of Nephrin in Glomeruli of Zucker Obese (ZO) and Zucker Lean (ZL) Rats (Piwkowska et al., 2013). The expression of nephrin detected by anti-nephrin antibodies did not change in ZO rats as compared to the control rats.

Immunohistochemistry Validation of Nephrin in Mouse Kidney (Toyama et al., 2012). Protein analysis for nephrin by immunohistochemistry with anti-nephrin antibodies in the kidney of wild-type or AMPD2-deficient mice at 2, 12 or 24 weeks of age. No difference between wild-type andAMPD2-deficient mice at any age was observed.

Regulated Expression Validation of Nephrin in Mouse Podocyte Cells Cultured in Normal Glucose (NG) Medium or High Glucose (HG) Medium (Huang et al., 2019). Western Blot analysis was used to access the protein expression level of nephrin with anti-nephrin antibodies. Nephrin expression was down-regulated by PEGF treatment (NGP or HGP), which was reversed by the addition of C3 transferase.
Documents Download
Request a Document
Protocol Information
NPHS1 Antibody (orb1239664)
Participating in our Biorbyt product reviews program enables you to support fellow scientists by sharing your firsthand experience with our products.
Login to Submit a Review